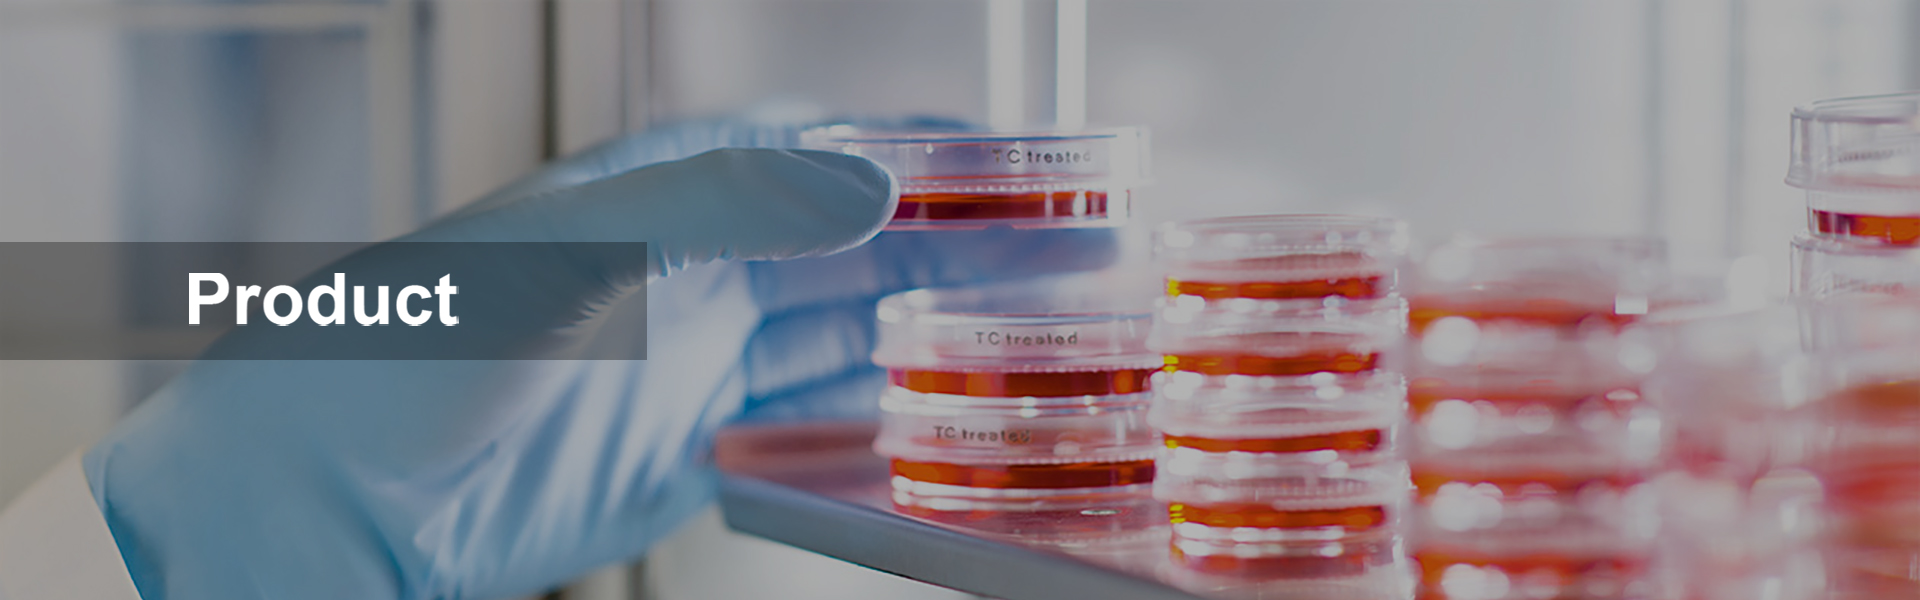

High quality medium for the cultivation of bacteria is at the core of various routine application in today’s laboratories. Hence, many downstream tasks and results directly depend on the performance of media preparation. Furthermore, an efficient process flow is important. This not only allows laboratories to save labor costs, but also frees manpower for less repetitive tasks.
YBOTECH Sampleprep automated culture media preparation & dispensing system is designed to approach these needs. It allows the rapid and gentle sterilization of 1~60L culture medium. Precise controlling and monitoring of temperature, time and pressure during the sterilization process guarantee constant high quality. The intuitive make it very easy for everyone to operate.
YBOTECH Smapleprep automated culture media preparation & dispensing system allows you to be flexible culture medium of high quality is rapidly available whenever needed. This minimizes the needed storage room, eliminates the management of shelf life time and therefore guarantees constant high medium quality.
YBOTECH Smapleprep automated culture media preparation & dispensing system is quickly set up. Insert the cuvette (container for media), dispense in the coupling water (water jacket between the cuvette and the vessel for efficient heat transfer) and you are ready to prepare your culture medium. Culture medium can be suspended and dissolved directly within Sampleprep system. The strong magnetic stirrer guarantees homogeneous mixing within the vessel and prevents coagulation. Alternatively, culture medium can be dissolved and pre-swelled using the Water Bath operation mode prior to sterilization. The intuitive, multilingual graphical user interface makes it very easy for everyone to use YBOTECH Smapleprep automated culture media preparation & dispensing system – no special training of the staff is required. Programs with user-defined parameter settings such as sterilization temperature, sterilization time or dispensing temperature can be saved and recalled.